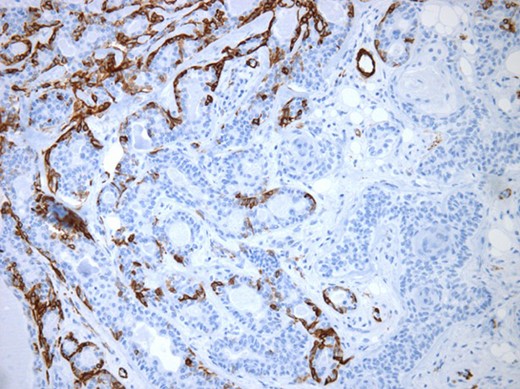
Myoepithelial cells highlighted by immunohistochemistry. SMA (×250).

-
PDF
- Split View
-
Views
-
Cite
Cite
Simon Brisebois, Myrna Chababi Atallah, Martin Borduas, Pierre-Hugues Fortier, A challenging case of squamous metaplasia in a pleomorphic adenoma: diagnostic and clinical pitfalls, Journal of Surgical Case Reports, Volume 2015, Issue 9, September 2015, rjv113, https://doi.org/10.1093/jscr/rjv113
Close - Share Icon Share
Abstract
Squamous metaplasia in a pleomorphic adenoma (PA) has been reported, but rarely has it been documented as being extensive enough to cause significant misdiagnosis. We present a case of a 37-year-old man presenting with a 1.7-cm minor salivary gland PA of the palate. It exhibited extensive squamous metaplasia mimicking a squamous cell carcinoma (SCC) on multiple preoperative biopsies. The final diagnosis was only made after a complete oncological excision with margins and free flap reconstruction. Florid squamous metaplasia in a PA, although rare, should be recognized and distinguished from SCC. Failure to differentiate these entities can lead to patient overtreatment.
INTRODUCTION
Pleomorphic adenoma (PA) is the most frequent benign tumor found in the salivary glands, accounting for 54–76% of all salivary neoplasia. The palate is a common site for minor salivary gland involvement. Being a mixed tumor, its histologic appearance can be enormously varied, showing epithelial ductal structures, myoepithelial cells and a diverse mesenchymal stroma, either myxoid or hyalinized, with chondroid, osteoid or adipose-like tissue [1]. We present a rare occurrence of extensive squamous metaplasia in a PA mimicking a squamous cell carcinoma (SCC).
CASE REPORT
A 37-year-old patient with no smoking or drinking history was referred to our oncology clinic in November 2012 for an SCC of the left palate. The lesion consisted of a 1-cm erythematous nodule of rubbery consistence. The rest of the examination was normal. A computed tomography scan confirmed a 13 × 11 mm lesion of the left soft palate without radiological evidence of deep invasion. The possibility of a minor salivary gland tumor was considered and a magnetic resonance imaging (MRI) scan was requested. A second biopsy was performed and the original pathology slides were reviewed. Both specimens suggested an SCC. The MRI scan revealed a submucosal lesion without any signs of local infiltration (Fig. 1). No regional disease was found. The lesion was staged as a T2N0 SCC of the buccal cavity and a curative oncologic surgery was proposed to the patient. Partial resection of the soft palate, maxilla and medial pterygoid plate with supracentimetric margins was undertaken as well as an ipsilateral selective neck dissection of levels 1–3. Closure of the deficit was with a fasciocutaneous antebrachial free flap and a prophylactic tracheostomy was performed. There were no complications. The tracheostomy was removed and the patient started eating on Day 7. He was discharged from the hospital on Day 8.

Post-gadolinium T1-weighted coronal section showing the lesion on the palate.
The surgical specimen showed a well-delineated submucosal nodule of 1.7 cm in the greatest diameter, without ulceration. Microscopically, this lesion appeared well defined with a central canal lined by keratinizing squamous epithelium without atypia (Fig. 2). In addition, we found confluent squamous foci with keratinizing centers (Fig. 3). The stroma was mostly fibrous, with occasional adipose and myxoid tissue. Only in the periphery of the lesion did we see a thin layer of normal ductal structures, highlighted by epithelial membrane antigen (EMA) positivity of the luminal cells, with immunochemistry studies (Fig. 4), whereas the other cellular component consisted of myoepithelial cells, highlighted by smooth muscle actin (SMA) and S100 protein (Fig. 5). No mucous secreting cell could be found. Keratin 5/6 and 903 were all positive for the whole specimen. The above-mentioned histopathologic findings helped to conclude the diagnosis of a PA with extensive squamous metaplasia. Margins were negative.

Well-circumscribed tumor on low power view. Hematoxylin and eosin (H&E ×25).

Solid sheets and massive squamous metaplasia with keratinization. Presence of adipose stroma. Hematoxylin and eosin (H&E ×40).

Luminal epithelial cells lining tubular structures highlighted by immunohistochemistry. EMA (×250).
Myoepithelial cells highlighted by immunohistochemistry. SMA (×250).
At 1-year follow-up, the patient has almost made a complete recovery. He presents a left-sided Eustachian tube dysfunction treated with a tympanostomy tube.
DISCUSSION
Focal squamous metaplasia has been reported in 20% of all PAs [2], but rarely of this magnitude. This finding could be linked to a region of necrosis in repair, such as after fine needle aspiration (FNA). A study by Dardick et al. [3] found that such metaplasia originated mostly from the acinar-intercalated duct cell complex in salivary glands parenchyma of rats after inducing ischemia and necrosis by arterial ligation. The process involved a dedifferentiation of the acinar cells and subsequent hyperplasia of acinar, duct luminal and myoepithelial cells. An accumulation of tonofilament with formation of desmosomes was then observed in the luminal and myoepithelial cells with keratinization of centrally located cells. However, no FNA was performed for diagnosis and no necrotic foci could be found to explain our findings. Thus, this metaplasia may have occurred spontaneously. Moreover, PA originating from the minor salivary glands of the palate tends to be particularly cellular and often lacks cartilaginous or myxoid differentiation making the pathological diagnosis even more difficult [4].
With access to the whole surgical specimen, the pathological features of a well-circumscribed submucosal lesion without epithelial dysplasia nor atypia in the keratinizing component, the presence of rare foci of myxoid and adipose stroma and the identification of ductal differentiation allowed us to diverge from our initial diagnosis. The immunohistochemical study was helpful to better identify the canalicular differentiation at the periphery of the nodule where luminal cells were labeled by EMA and the myoepithelial component was revealed by SMA and S100 protein.
Similar to our report, Lam et al. reported a case of a 52-year-old man who presented with a 2-cm nodule of the right palate. This lesion was diagnosed as a PA with extensive squamous metaplasia, as 95% of the epithelial content of the tumor was composed of sheets of squamous cells with formation of cysts [5]. Two other cases of oral cavity PA with substantial squamous metaplasia have been reported, but these lesions had been evolving for many years. Hence, a diagnosis of a benign lesion was probably easier to entertain [6, 7]. In all of these cases, a preliminary diagnosis was made using FNA. In our patient, the young age, combined with the absence of risk factors for SCC, was in favor of a benign etiology.
This case represents a rare variant of a common pathology that we need to recognize. Misdiagnosis can lead to overtreatment of these lesions using more aggressive surgical approach and/or radiation therapy. Unfortunately, the differential diagnosis is sometimes limited by the quantity of tissue available. The key to avoiding misdiagnosis is to keep a high level of suspicion in the face of the clinical context suggesting a benign lesion, even with adverse pathological findings.
Our patient was treated with an aggressive surgery and fortunately did not suffer from any significant complications. A more accurate preoperative diagnosis of the lesion would have avoided neck surgery and allowed us to perform a more conservative resection, thus avoiding the use of a free flap reconstruction.
In conclusion, squamous metaplasia can potentially occur extensively in a PA and should be distinguished from an SCC. The limitations of our biopsy techniques in this matter should be recognized.
CONFLICT OF INTEREST STATEMENT
None declared.